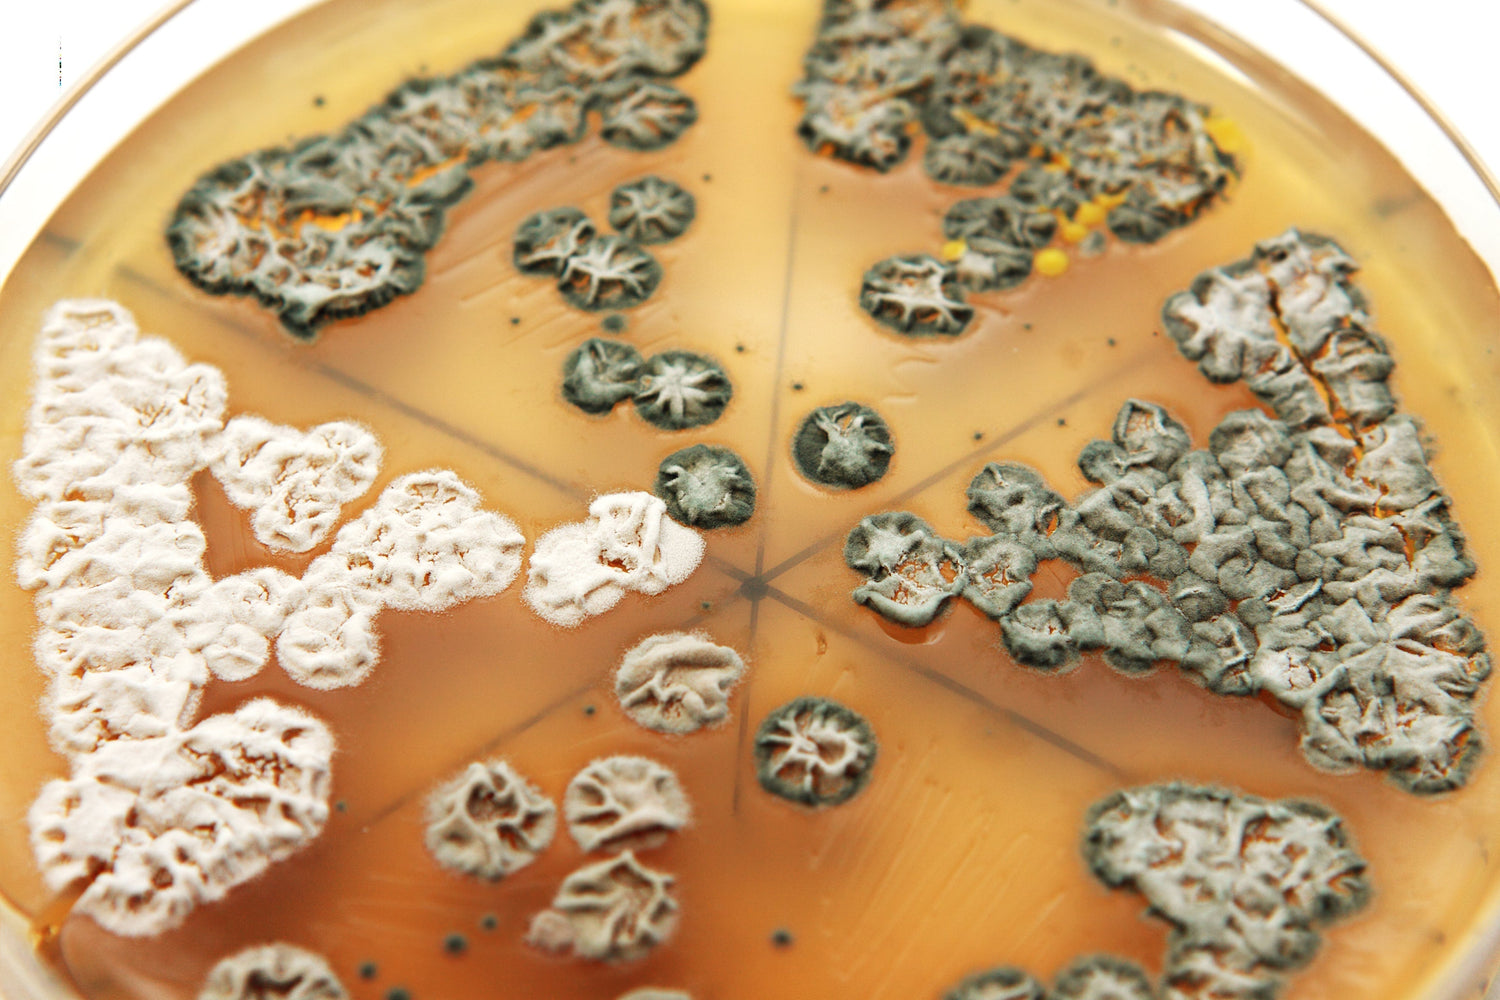
The Mycotoxin Lie That Hijacked Specialty Coffee

Let’s talk about the “Mycotoxin-Free” marketing trend.
There’s a growing trend in the coffee industry where some brands have built their entire identity around being “mycotoxin-free.” What they don’t tell you is that these claims are often based on a single lab test from a single batch of coffee, done once or twice a year—often on coffee they roasted months ago. That’s it.
They are not testing every roast. They are not testing every shipment. And they are certainly not testing every burlap bag of green coffee.
Comprehensive third-party testing—done even on a small 100-gram sample—can cost around $500 per test. A standard burlap bag of green coffee weighs 60–70 kilograms (132–154 pounds), and a 100-gram test sample represents just 0.15% of that volume. So even if a company claimed to test every single bag (which, to be clear, they are absolutely not doing), they’d still be testing only a fraction of each one.
The certificate they show you? It reflects the condition of a tiny sliver of one lot, on one day—not the full batch, not ongoing production, and certainly not every roast. It’s not proof of product-wide safety. It’s a sampling shortcut dressed up as a guarantee.
Using fear to sell coffee is dishonest—and harmful.
Many of these companies target vulnerable people—especially those dealing with chronic illness—who have been told by someone (sometimes a questionable “expert”) that they can’t drink coffee due to mycotoxins. Instead of educating or empowering, these companies exploit that fear to sell a false sense of security.
Some of them are run or endorsed by people claiming to be doctors. And while they may very well be licensed physicians, having “Dr.” in front of your name doesn’t make your business ethical. Doctors are human. They need and want money like everyone else. There’s no rule that says they can’t build a business on manipulation or profit from fear.
Now even good companies are forced to play along.
Because of how widespread this messaging has become, reputable roasters—brands that have always done things the right way—now feel pressured to add “mycotoxin-free” to their packaging just to stay competitive. Not because their practices changed, but because consumer expectations have been distorted by fear-driven marketing.
This isn’t about science anymore. It’s about market manipulation. Consumers have been trained to believe that unless a coffee brand markets itself as “mycotoxin-free,” it must be unsafe.
That’s dangerous thinking. And it’s bad for the industry.
Here’s the truth:
- High-quality, specialty-grade coffee, when responsibly sourced, harvested, and stored, rarely contains harmful levels of mycotoxins.
- Mycotoxins form in coffee only under excessive moisture, contamination, or poor post-harvest handling—issues that are easily avoided through proper sourcing and storage.
- Our strict moisture control protocols, lot-by-lot internal testing, roasting at temperatures above 415°F, and sourcing only specialty-grade organic coffee do far more to protect your health than any one-off third-party certificate ever could.
We do test every lot we receive, but not as a marketing gimmick—we do it because it's part of a holistic quality control process that starts with sourcing the right coffee in the first place.
We don’t sell fear. We sell transparency, safety, and integrity.
If you’ve been misled by the hype, we understand. That’s exactly how fear-based marketing works.
But at Artizan Coffee, we believe you deserve better.
So we’ll keep doing the hard work—batch by batch, roast by roast—to earn your trust.
Because “mycotoxin-free” shouldn’t be a feature. It should be a given.